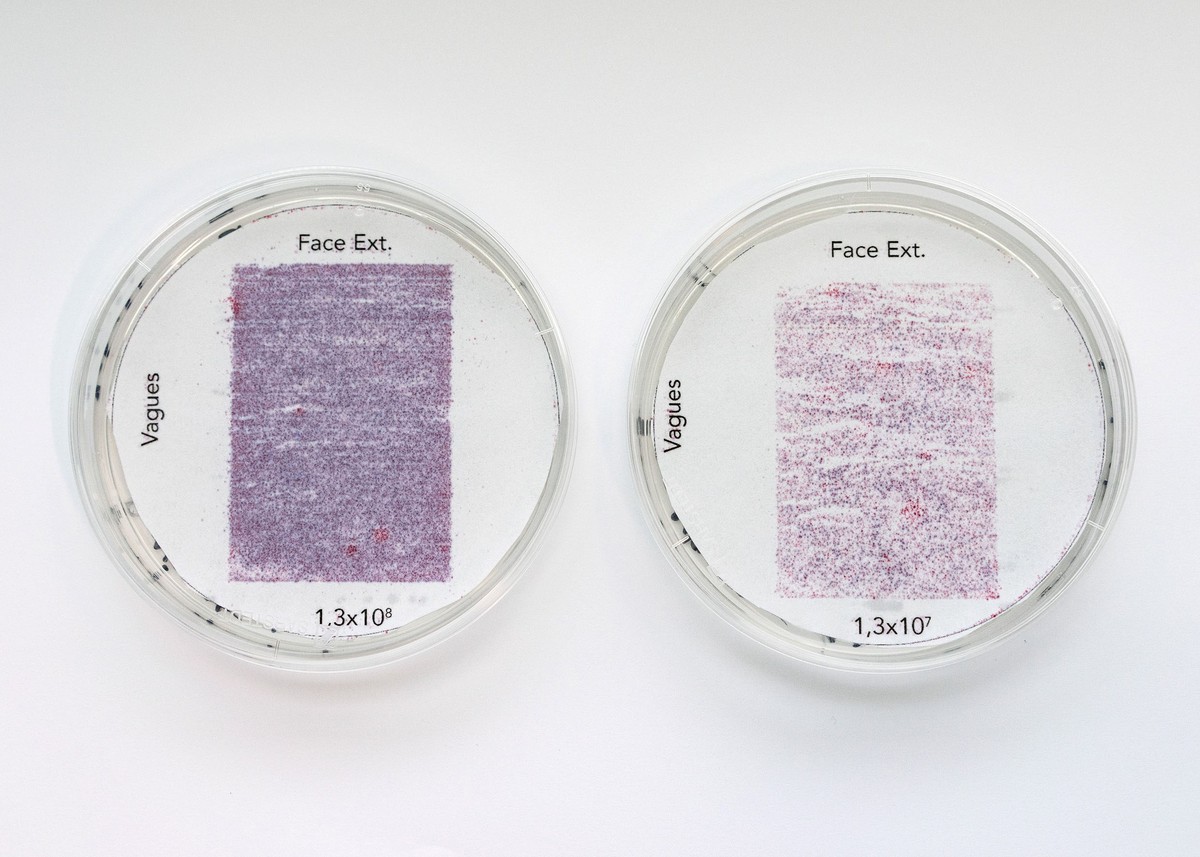
Ultrachrome
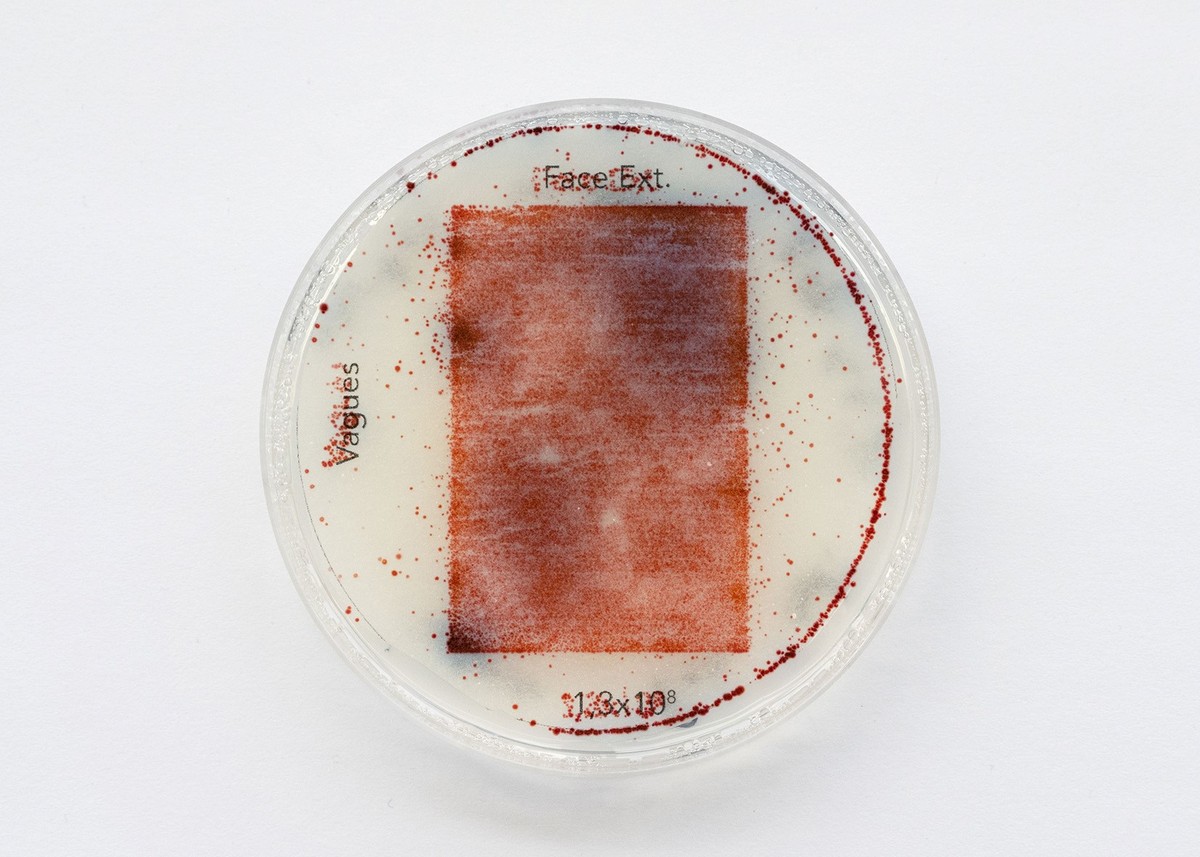
Ultrachrome
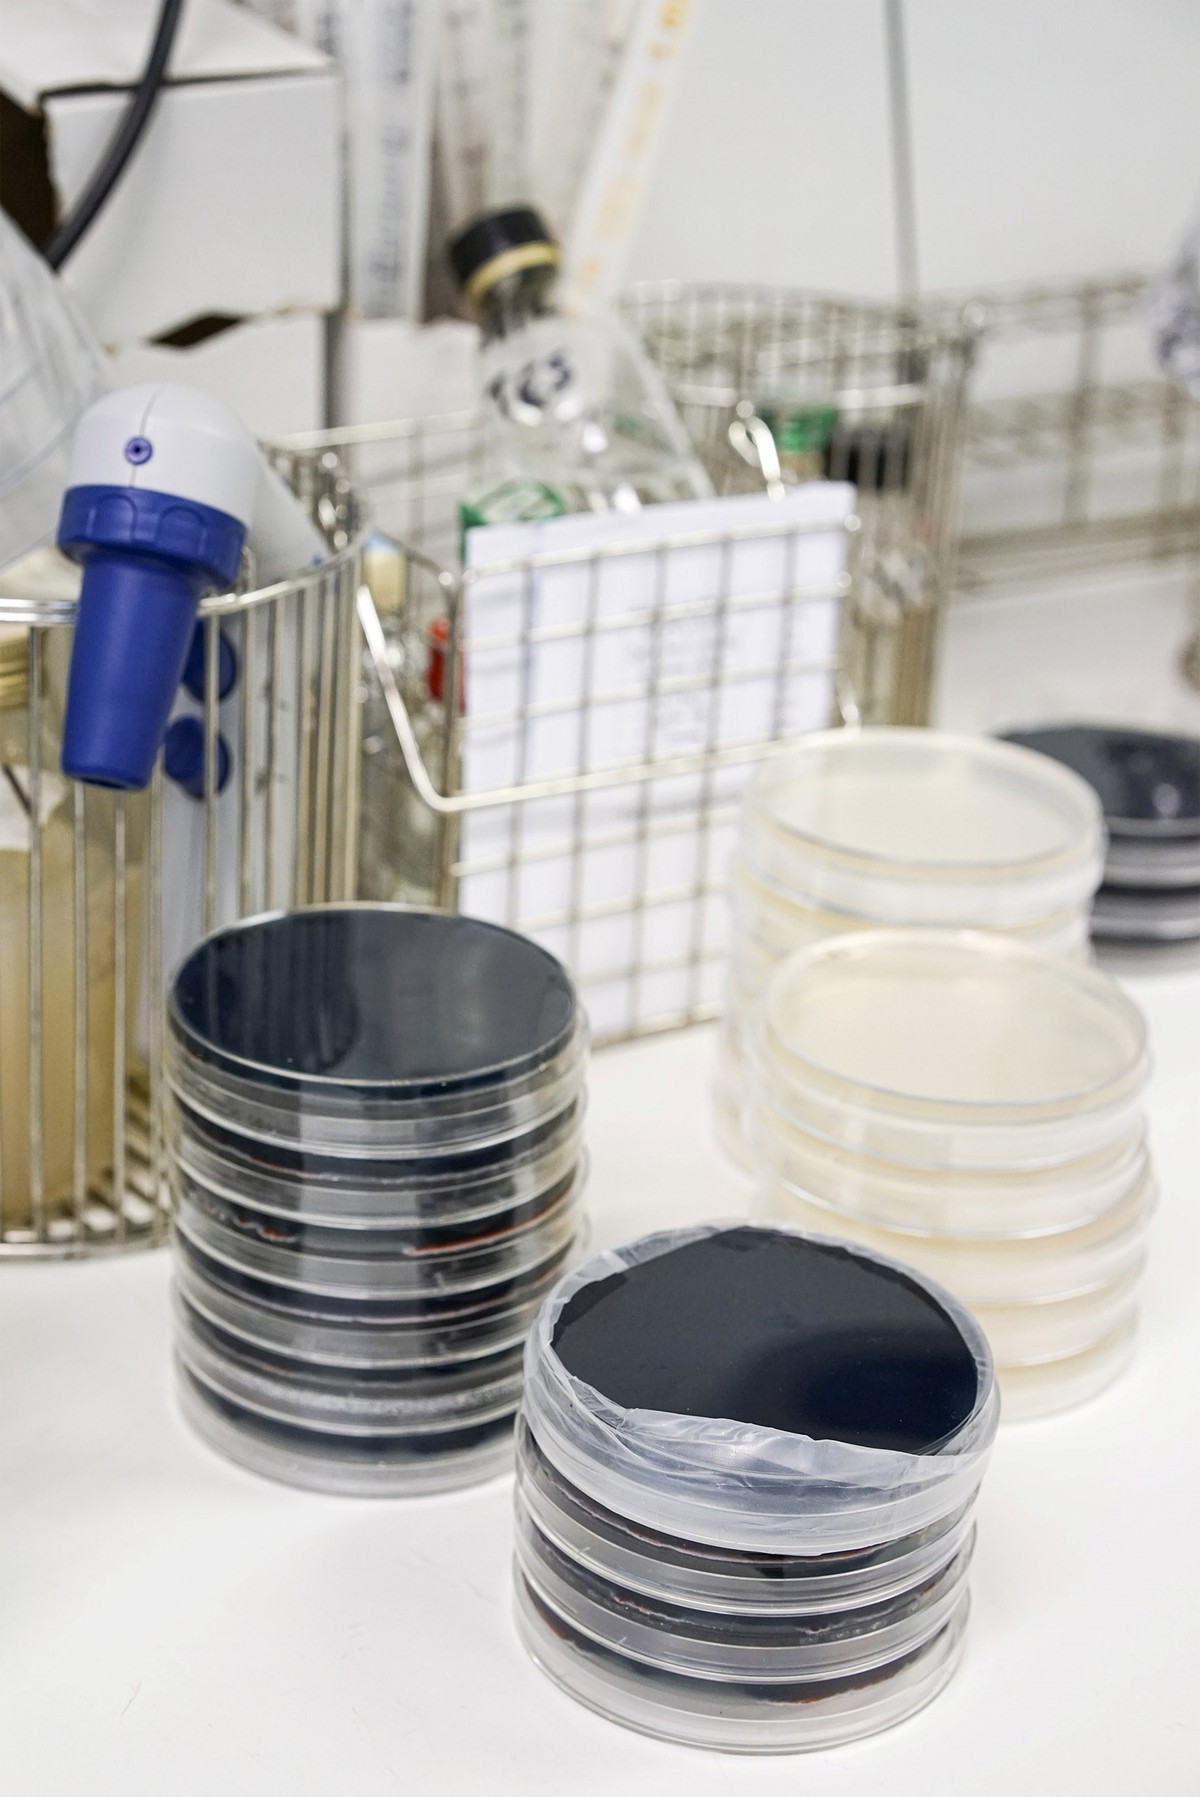
Ultrachrome

Olivier Sola
Ultrachrome - Installation - 2020
présentée dans le cadre de l'exposition Panorama 22 - Les sentinelles



Installation
En opérant littéralement par la contamination et la pollution de la technologie de l’impression jet d’encre, technologie privilégiée de matérialisation de l’image numérique, je cherche à questionner la matière même qui constitue l’image photographique d’aujourd’hui.
Par ces deux actions renvoyant étymologiquement à la notion de souillure et donc au passage d’un état pensé comme pur à un état pensé comme impur je cherche également à interroger les implications politiques et philosophiques des outils et mécanismes de fabrication de l’image numérique. Recherche d’une image dont l’exactitude et le contenu en information seraient supérieurs au réel lui même, recherche d’une standardisation et d’une reproductibilité exempte d’erreurs, modèle économique de production (smartphones, APN, imprimantes, encres, …) reposant sur l’obsolescence, le gaspillage et sur des industries et entreprises polluantes ainsi que socialement et fiscalement prédatrices, etc…
En produisant des images imprévisibles, uniques et imparfaites grâce à ces deux actions et par le détournement d’un outil résolument pictural fonctionnant par projection de pigment sur une surface plane (l’imprimante jet d’encre), il s’agit également de questionner la nature même des oeuvres créées ainsi que la porosité des frontières qui séparent l’image photographique de l’image peinte ou dessinée.
Avec deux équipes de chercheurs de l’université de Lille nous avons, pour ce projet, travaillé à la mise au point, d’une part, d’une encre noire composée intégralement de particules de pollution et, d’autre part, d’une encre vivante composée d’une souche bactérienne produisant sur le papier un pigment dont la couleur varie du magenta au bleu.
Deux types d’images sont ici montrées, les premières, disposées au mur, qu’elles soient issues de l’impression de bactéries ou de particules de pollution, sont inertes, figées dans le temps. Les secondes, issues de l’impression de bactéries et disposées sur socle sont maintenues vivantes et évoluent tout au long de l’exposition de leur apparition jusqu’à leur inéluctable destruction.
Olivier Sola a débuté son parcours artistique par une licence en Arts plastiques à l’université de Rennes 2, prenant en parallèle des cours de photographie à l’École régionale des Beaux-Arts de Rennes. Il a ensuite intégré l’École nationale supérieure de Photographie d’Arles et a pu bénéficier, lors de ce cursus, d’un programme d’échange à la School of Visual Arts de New York. Il entre au Fresnoy – Studio national des arts contemporains en octobre 2018. Son travail a été exposé dans différents lieux et événements lors d’expositions collectives et personnelles tels que, le festival des Rencontres de la photographie d’Arles, la Friche Belle de Mai à Marseille ou le festival des Nuits photographiques à Paris.
Production
Partenaires
Remerciements
Éric Prigent, Luc-Jérôme Bailleul, Pascal Buteaux, Bertrand Scalabre, Beat Gysin, Madeleine Van Doren, Cyprien Quairiat, Olivier Anselot, à toute l’équipe du Fresnoy et aux promotions André S. Labarthe et Jonas Mekas.
Ce projet a été réalisé dans le cadre d’une collaboration franco-belge de l’UMR transfrontalière BioEcoAgro, impliquant les chercheurs Valérie Leclère et Marlène Chollet de l’Institut Charles Viollette de l’Université de Lille et Philippe Jacques du Teaching and Research Centre TERRA de l’Université de Liège GbxABT, ainsi que les chercheurs Pierre Leblond de l’UMR INRAE DynAMic de l’Université de Lorraine, Xavier Mercier et Nicolas Visez sous la direction de Laurent Gasnot et Benjamin Hanoune du laboratoire PC2A de l’Université de Lille/CNRS.